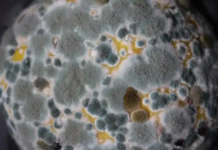

കേരള ആരോഗ്യരംഗത്ത് സമഗ്ര പുരോഗതി കൈവരിക്കാന് ആര്ദ്രം മിഷന് വഴി സാധിച്ചെന്നും ലോകമെമ്പാടുമുള്ള മലയാളികള്ക്ക് അഭിമാനമാണ് കേരളത്തിലെ ആരോഗ്യ മേഖല എന്നും മുഖ്യമന്ത്രി പിണറായി വിജയൻ.
സര്ക്കാരിന്റെ 100 ദിന കര്മ്മപദ്ധതികളുടെ ഭാഗമായി 25 കോടി രൂപ ചെലവില് സംസ്ഥാനത്തെ 50 ആരോഗ്യ സ്ഥാപനങ്ങളിലെ വിവിധ പദ്ധതികളാണ് മുഖ്യമന്ത്രി ഉദ്ഘാടനം ചെയ്തത്.
കഴിഞ്ഞ സര്ക്കാരിന്റെ കാലത്ത് 856 പ്രാഥമിക ആരോഗ്യ കേന്ദ്രങ്ങളെ കുടുംബാരോഗ്യ കേന്ദ്രങ്ങളാക്കി ഉയര്ത്താനാണ് പദ്ധതി തയ്യാറാക്കിയത്. അതില് 474 എണ്ണം പൂര്ത്തീകരിച്ചു. ബാക്കിയുള്ളവയില് ആറ് സ്ഥാപനങ്ങളാണ് കുടുംബാരോഗ്യ കേന്ദ്രങ്ങള് ആയി ഇപ്പോള് ഉയര്ത്തുന്നത്. വിദഗ്ധ ചികിത്സയും മികച്ച അടിസ്ഥാന സൗകര്യങ്ങളും ആണ് ഈ കുടുംബാരോഗ്യ കേന്ദ്രങ്ങളില് ഒരുക്കിയിരിക്കുന്നത്. 2.5 കോടി രൂപ ചെലവില് വിവിധ സബ് സെന്ററുകള് ഹെല്ത്ത്കെയര് വെല്നെസ് സെന്ററുകള് ആക്കി മാറ്റുകയാണ്. ഇത്തരത്തില് 28 സെന്ററുകള് ആണ് സംസ്ഥാനത്ത് പ്രവര്ത്തനം ആരംഭിക്കുന്നതെന്നും അദ്ദേഹം പറഞ്ഞു.
ഇടപ്പള്ളി പ്രാഥമികാരോഗ്യകേന്ദ്രത്തിനോട് ചേര്ന്നാണ് എറണാകുളം ജില്ല കേന്ദ്രീകരിച്ചുള്ള റീജിയണല് വാക്സിന് സ്റ്റോറിന്റെ നിര്മ്മാണം പൂര്ത്തിയായിരിക്കുന്നത്. എറണാകുളം ജില്ലക്ക് പുറമെ, തൃശൂര്, പാലക്കാട്, ഇടുക്കി, കോട്ടയം ജില്ലകളിലേക്ക് കൂടിയുള്ള വാക്സിനുകള് ഇടപ്പള്ളിയിലെ റീജിയണല് വാക്സിന് സ്റ്റോറിലാണ് സൂക്ഷിക്കുക. ഇവിടെനിന്നും ജില്ലാ വാക്സിന് സ്റ്റോറിലേക്കും അവിടെ നിന്നും താഴെത്തട്ടിലേക്കും വിതരണം ചെയ്യും. സംസ്ഥാനത്തുതന്നെ എറ്റവും വലിയ റീജിയണല് വാക്സിന് സ്റ്റോറാണ് ഇടപ്പള്ളിയിലുള്ളത്.
വാക്കിംഗ് കൂളര്, വാക്കിംഗ് ഫ്രീസര്, ലോജിസ്റ്റിക്, കോള്ഡ് ചെയിന് വര്ക്ക്ഷോപ്പ് എന്നിവക്കുള്ള സൗകര്യങ്ങളാണ് ഇവിടെ നല്കിയിരിക്കുന്നത്.
തൈക്കാവ്, പിണര്മുണ്ട, ഉളിയന്നൂര് കുടുംബക്ഷേമ ഉപകേന്ദ്രങ്ങളെ ഹെല്ത്ത് ആന്റ് വെല്നെസ് സെന്ററുകളാക്കി ഉയര്ത്തുന്നതിന് ഓരോ കേന്ദ്രങ്ങള്ക്കും ശരാശരി ദേശീയ ആരോഗ്യദൗത്യം മുഖേന 7 ലക്ഷം രൂപ വീതം ചെലവഴിച്ചാണ് പ്രവര്ത്തനങ്ങള് പൂര്ത്തിയാക്കിയത്. കടവന്ത്ര, മങ്ങാട്ടുമുക്ക് ആരോഗ്യകേന്ദ്രങ്ങളെയാണ് നഗര കുടുംബാരോഗ്യകേന്ദ്രങ്ങളാക്കി ഉയര്ത്തിയിരിക്കുന്നത്.